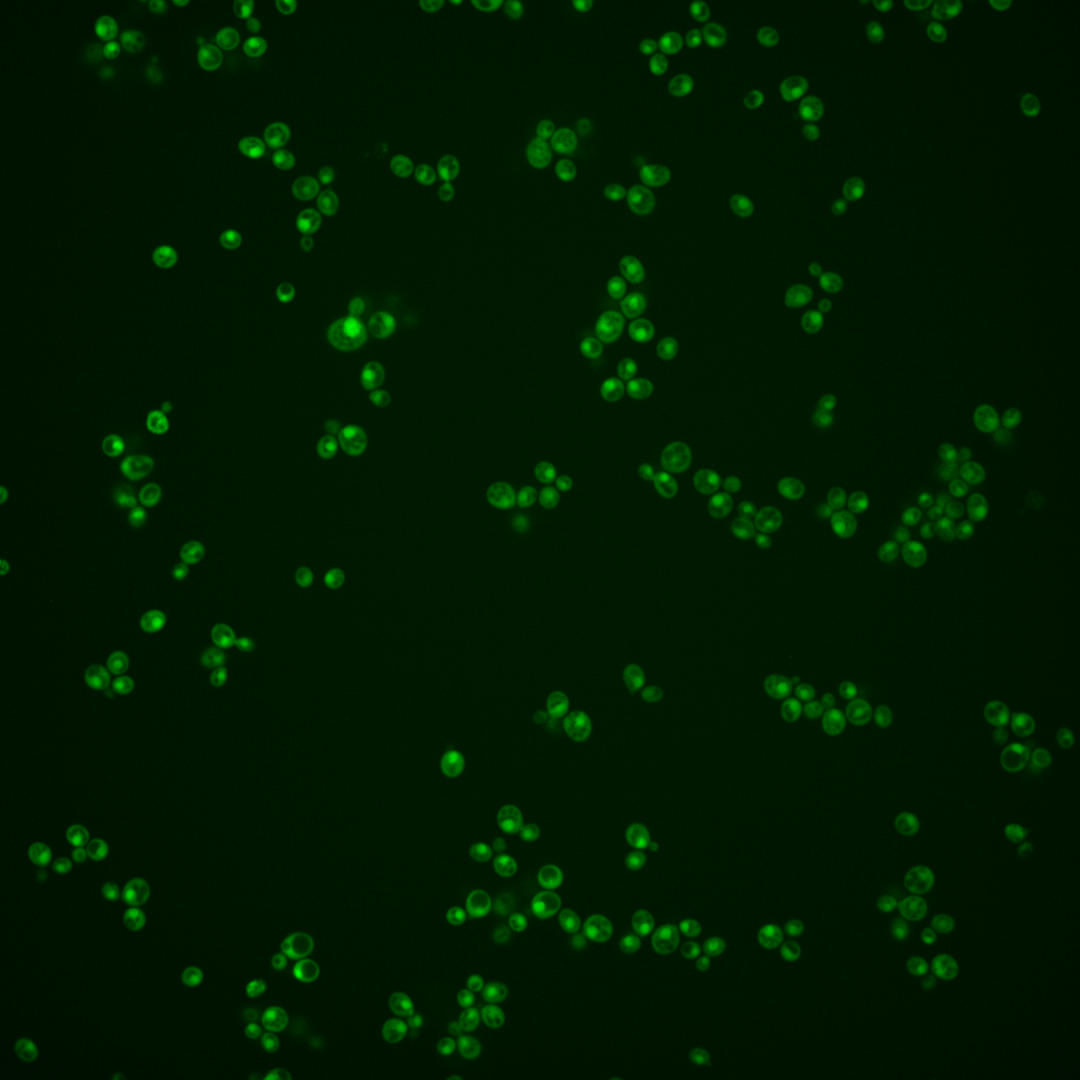
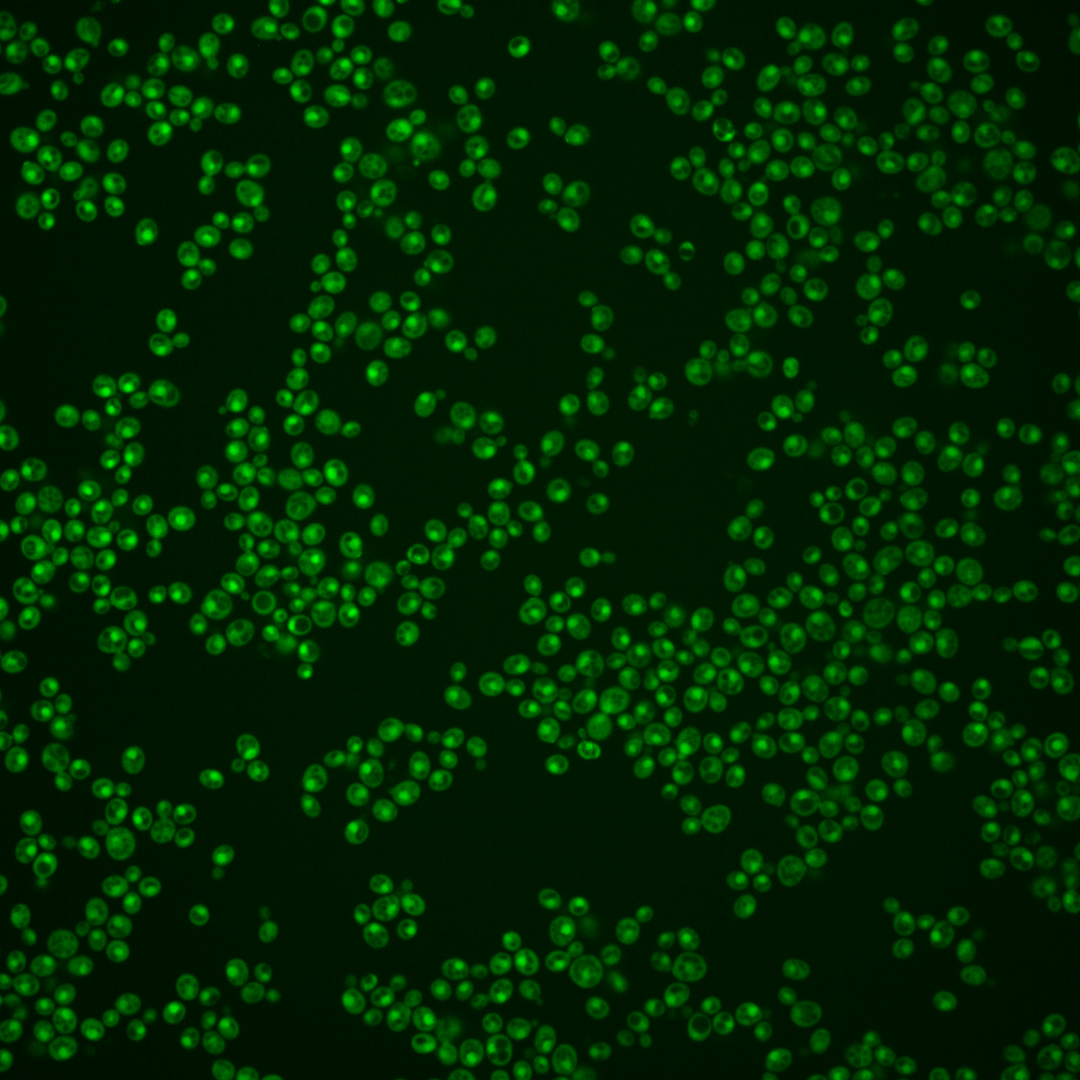
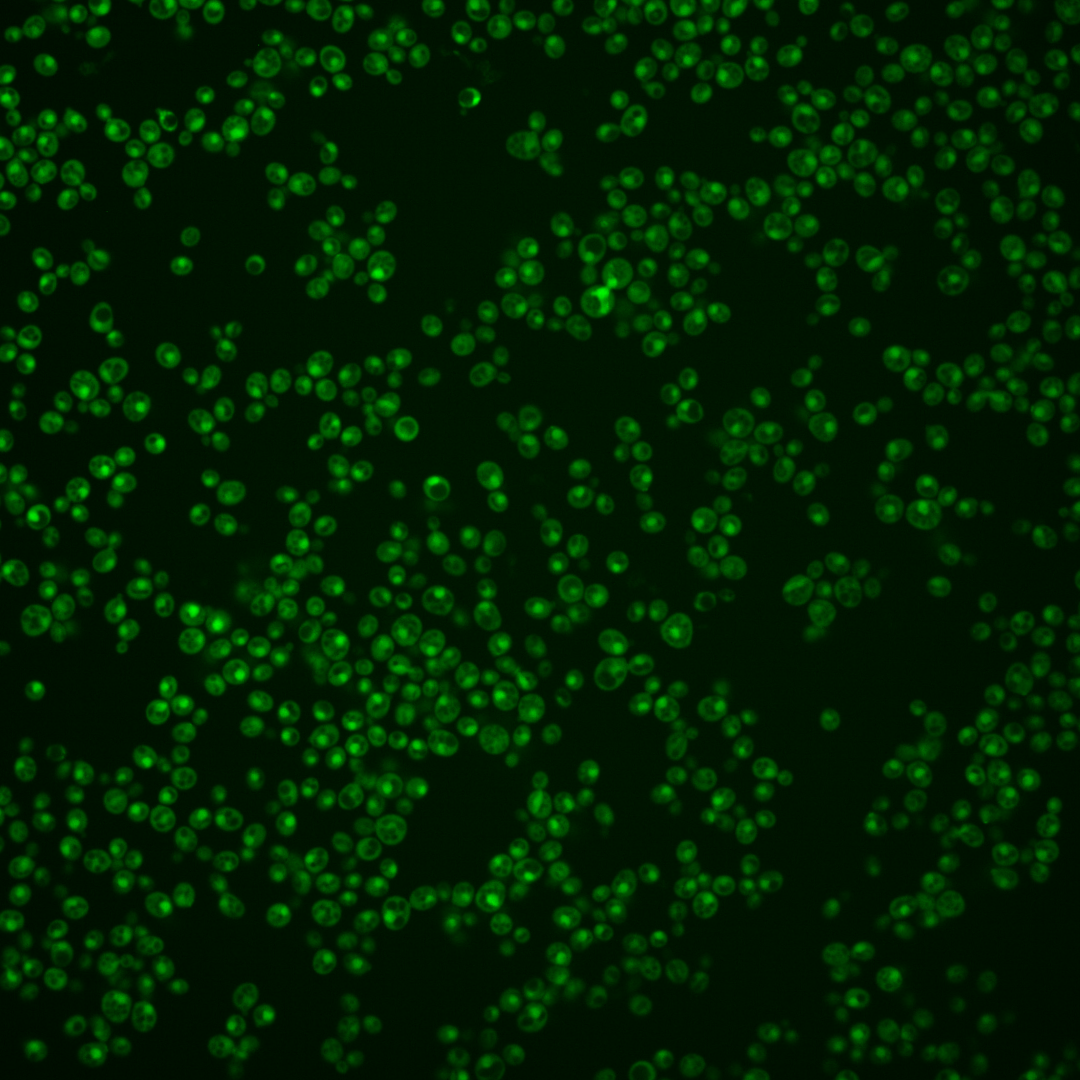
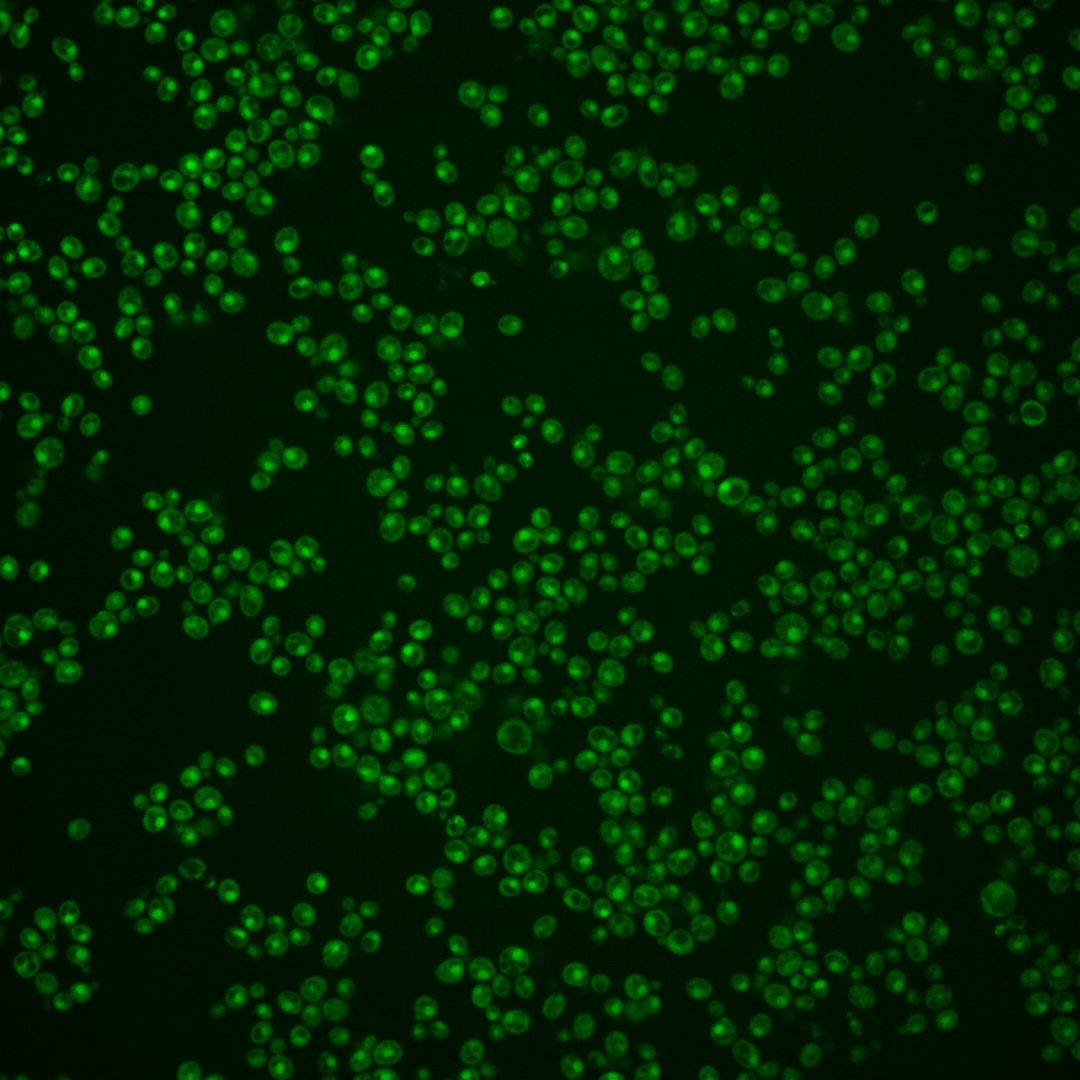
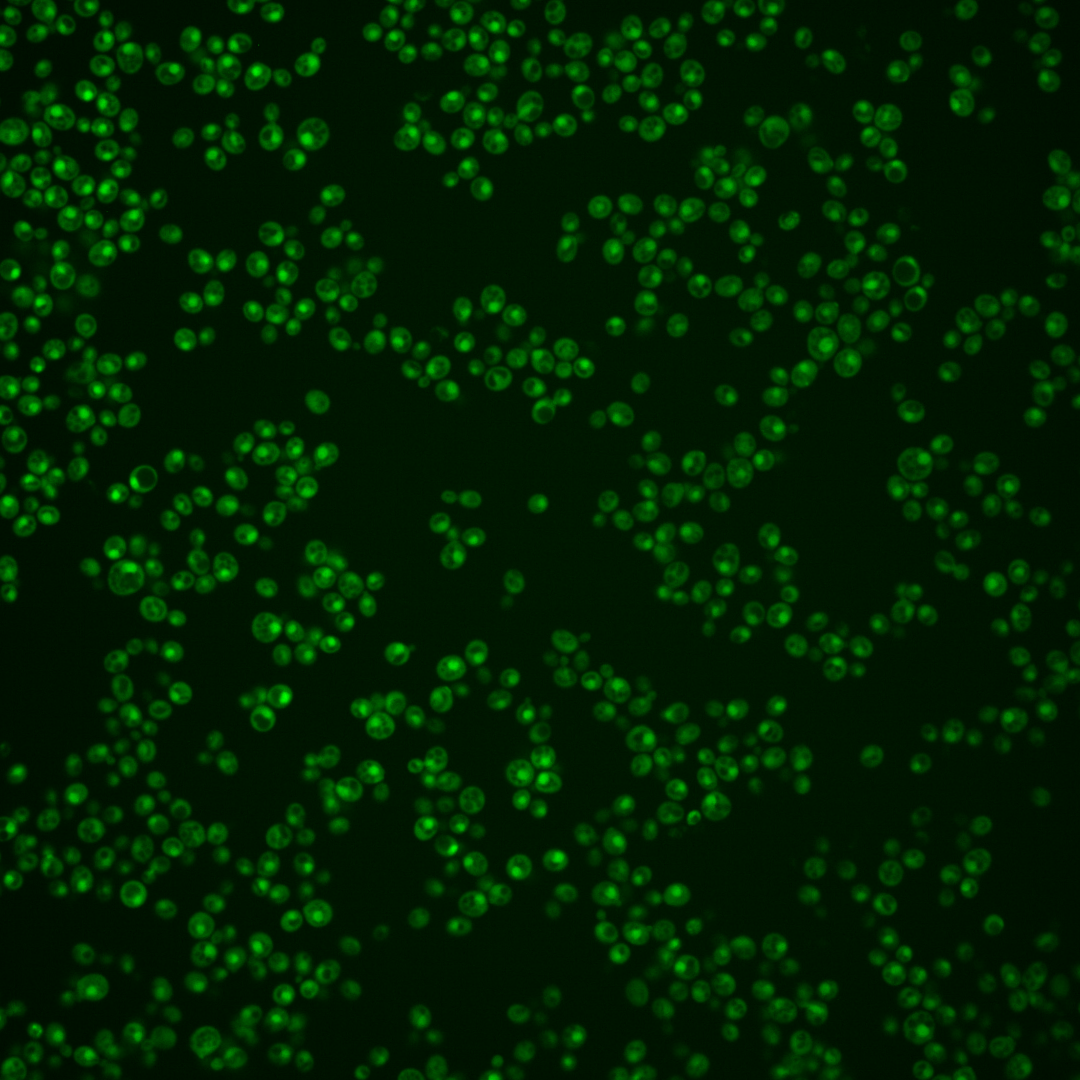

| Standard name | |
|---|---|
| Human Ortholog | |
| Description | Cyclin-dependent kinase; has ten cyclin partners; involved in regulating the cellular response to nutrient levels and environmental conditions and progression through the cell cycle; human lissencephaly-associated homolog CDK5 functionally complements null mutation |
Micrographs




















































































Sub-cellular Localization
Yeast GFP Assignment
Protein Abundance
Localization Change
External localization resources
| ensLOC | DeepLoc | |||||||||||||||||||||||
|---|---|---|---|---|---|---|---|---|---|---|---|---|---|---|---|---|---|---|---|---|---|---|---|---|
| Localization | WT1 | WT2 | WT3 | RAP60 | RAP140 | RAP220 | RAP300 | RAP380 | RAP460 | RAP540 | RAP620 | RAP700 | HU80 | HU120 | HU160 | rpd3Δ_1 | rpd3Δ_2 | rpd3Δ_3 | WT1 | WT2 | WT3 | AF100 | AF140 | AF180 |
| Cortical Patches | 0 | 0 | 0 | 1 | 0 | 1 | 0 | 2 | 0 | 1 | 0 | 1 | 0 | 1 | 0 | 1 | 0 | 0 | 0 | 0 | 1 | 0 | 0 | 1 |
| Bud | 1 | 0 | 0 | 0 | 0 | 0 | 3 | 0 | 0 | 0 | 3 | 1 | 0 | 0 | 0 | 0 | 0 | 1 | 5 | 6 | 7 | 20 | 25 | 27 |
| Bud Neck | 0 | 0 | 0 | 0 | 0 | 0 | 0 | 0 | 0 | 0 | 0 | 0 | 0 | 0 | 0 | 0 | 0 | 0 | 1 | 0 | 2 | 1 | 4 | 12 |
| Bud Site | 0 | 0 | 0 | 0 | 0 | 0 | 0 | 0 | 0 | 0 | 1 | 0 | 0 | 0 | 0 | 0 | 0 | 0 | – | – | – | – | – | – |
| Cell Periphery | 0 | 0 | 0 | 0 | 0 | 0 | 0 | 0 | 0 | 1 | 0 | 0 | 0 | 0 | 1 | 7 | 4 | 2 | 0 | 0 | 1 | 0 | 0 | 0 |
| Cytoplasm | 40 | 75 | 57 | 37 | 74 | 83 | 92 | 51 | 44 | 32 | 46 | 32 | 104 | 128 | 145 | 239 | 106 | 208 | 22 | 26 | 45 | 51 | 41 | 59 |
| Endoplasmic Reticulum | 1 | 0 | 3 | 0 | 2 | 2 | 0 | 1 | 2 | 0 | 0 | 0 | 2 | 2 | 0 | 14 | 2 | 8 | 1 | 0 | 3 | 0 | 2 | 3 |
| Endosome | 0 | 0 | 2 | 2 | 1 | 6 | 2 | 4 | 1 | 2 | 4 | 2 | 2 | 0 | 0 | 1 | 0 | 0 | 1 | 3 | 4 | 7 | 13 | 9 |
| Golgi | 0 | 0 | 0 | 2 | 10 | 4 | 7 | 4 | 3 | 4 | 2 | 3 | 1 | 1 | 7 | 3 | 1 | 0 | 0 | 0 | 1 | 0 | 1 | 1 |
| Mitochondria | 2 | 0 | 0 | 0 | 0 | 7 | 17 | 10 | 23 | 13 | 39 | 10 | 0 | 2 | 1 | 2 | 2 | 3 | 0 | 0 | 1 | 0 | 4 | 2 |
| Nucleus | 13 | 20 | 68 | 119 | 125 | 109 | 159 | 104 | 96 | 91 | 105 | 116 | 66 | 99 | 97 | 25 | 8 | 7 | 88 | 110 | 138 | 167 | 198 | 212 |
| Nuclear Periphery | 0 | 0 | 0 | 0 | 0 | 1 | 2 | 0 | 0 | 0 | 0 | 0 | 0 | 0 | 0 | 0 | 0 | 0 | 1 | 0 | 1 | 1 | 3 | 2 |
| Nucleolus | 1 | 0 | 0 | 1 | 0 | 2 | 7 | 6 | 3 | 2 | 13 | 4 | 1 | 0 | 0 | 0 | 0 | 0 | 2 | 0 | 1 | 6 | 10 | 12 |
| Peroxisomes | 0 | 0 | 0 | 0 | 0 | 0 | 0 | 0 | 0 | 0 | 0 | 0 | 0 | 0 | 1 | 0 | 0 | 0 | 0 | 0 | 0 | 0 | 0 | 0 |
| SpindlePole | 0 | 0 | 0 | 0 | 0 | 0 | 0 | 0 | 0 | 0 | 0 | 0 | 0 | 0 | 0 | 0 | 0 | 0 | 1 | 1 | 4 | 6 | 10 | 13 |
| Vac/Vac Membrane | 77 | 75 | 118 | 97 | 108 | 134 | 147 | 120 | 90 | 54 | 108 | 97 | 141 | 183 | 194 | 234 | 39 | 76 | 8 | 13 | 31 | 30 | 43 | 65 |
| Unique Cell Count | 112 | 124 | 206 | 232 | 278 | 301 | 396 | 271 | 228 | 184 | 282 | 243 | 264 | 365 | 399 | 404 | 133 | 262 | 139 | 165 | 250 | 299 | 365 | 431 |
| Labelled Cell Count | 135 | 170 | 248 | 259 | 320 | 349 | 436 | 302 | 262 | 200 | 321 | 266 | 317 | 416 | 446 | 526 | 162 | 305 | 139 | 165 | 250 | 299 | 365 | 431 |
Yeast GFP Assignment
Protein Abundance
| Screen | WT1 | WT2 | WT3 | RAP60 | RAP140 | RAP220 | RAP300 | RAP380 | RAP460 | RAP540 | RAP620 | RAP700 | HU80 | HU120 | HU160 | rpd3Δ_1 | rpd3Δ_2 | rpd3Δ_3 | AF100 | AF140 | AF180 |
|---|---|---|---|---|---|---|---|---|---|---|---|---|---|---|---|---|---|---|---|---|---|
| Mean Cell GFP Intensity (1e-4) | 9.3 | 13.2 | 11.7 | 11.5 | 11.8 | 10.5 | 10.4 | 11.0 | 9.8 | 10.2 | 9.7 | 10.1 | 12.5 | 12.5 | 13.0 | 16.8 | 16.0 | 15.9 | 11.8 | 12.3 | 12.2 |
| Std Deviation (1e-4) | 1.5 | 2.3 | 1.6 | 1.6 | 1.7 | 1.8 | 1.9 | 1.8 | 1.9 | 1.8 | 2.0 | 2.1 | 2.1 | 2.2 | 2.1 | 2.9 | 3.3 | 3.0 | 1.8 | 1.7 | 1.9 |
| Intensity Change (Log2) | – | – | – | -0.03 | 0.01 | -0.16 | -0.17 | -0.1 | -0.25 | -0.21 | -0.28 | -0.21 | 0.09 | 0.09 | 0.15 | 0.52 | 0.45 | 0.44 | 0.01 | 0.07 | 0.06 |
Localization Change
| Localization | RAP60 | RAP140 | RAP220 | RAP300 | RAP380 | RAP460 | RAP540 | RAP620 | RAP700 | HU80 | HU120 | HU160 | rpd3Δ_1 | rpd3Δ_2 | rpd3Δ_3 |
|---|---|---|---|---|---|---|---|---|---|---|---|---|---|---|---|
| Cortical Patches | 0 | 0 | 0 | 0 | 0 | 0 | 0 | 0 | 0 | 0 | 0 | 0 | 0 | 0 | 0 |
| Bud | 0 | 0 | 0 | 0 | 0 | 0 | 0 | 0 | 0 | 0 | 0 | 0 | 0 | 0 | 0 |
| Bud Neck | 0 | 0 | 0 | 0 | 0 | 0 | 0 | 0 | 0 | 0 | 0 | 0 | 0 | 0 | 0 |
| Bud Site | 0 | 0 | 0 | 0 | 0 | 0 | 0 | 0 | 0 | 0 | 0 | 0 | 0 | 0 | 0 |
| Cell Periphery | 0 | 0 | 0 | 0 | 0 | 0 | 0 | 0 | 0 | 0 | 0 | 0 | 0 | 0 | 0 |
| Cytoplasm | -3.0 | -0.3 | 0 | -1.2 | -2.3 | -2.1 | -2.4 | -3.0 | -3.8 | 2.7 | 1.8 | 2.1 | 7.4 | 9.4 | 11.2 |
| Endoplasmic Reticulum | 0 | 0 | 0 | 0 | 0 | 0 | 0 | 0 | 0 | 0 | 0 | 0 | 1.4 | 0 | 0 |
| Endosome | 0 | 0 | 0 | 0 | 0 | 0 | 0 | 0 | 0 | 0 | 0 | 0 | 0 | 0 | 0 |
| Golgi | 0 | 0 | 0 | 0 | 0 | 0 | 0 | 0 | 0 | 0 | 0 | 0 | 0 | 0 | 0 |
| Mitochondria | 0 | 0 | 0 | 3.0 | 0 | 4.7 | 3.9 | 5.6 | 0 | 0 | 0 | 0 | 0 | 0 | 0 |
| Nucleus | 3.9 | 2.7 | 0.7 | 1.7 | 1.2 | 2.0 | 3.3 | 1.0 | 3.2 | -1.9 | -1.5 | -2.3 | -8.7 | -5.8 | -8.9 |
| Nuclear Periphery | 0 | 0 | 0 | 0 | 0 | 0 | 0 | 0 | 0 | 0 | 0 | 0 | 0 | 0 | 0 |
| Nucleolus | 0 | 0 | 0 | 0 | 0 | 0 | 0 | 3.1 | 0 | 0 | 0 | 0 | 0 | 0 | 0 |
| Peroxisomes | 0 | 0 | 0 | 0 | 0 | 0 | 0 | 0 | 0 | 0 | 0 | 0 | 0 | 0 | 0 |
| SpindlePole | 0 | 0 | 0 | 0 | 0 | 0 | 0 | 0 | 0 | 0 | 0 | 0 | 0 | 0 | 0 |
| Vacuole | -3.2 | -4.0 | -2.8 | -4.7 | -2.8 | -3.7 | -5.5 | -4.2 | -3.7 | -0.8 | -1.6 | -2.0 | 0.2 | -5.0 | -6.2 |
External localization resources
Images






























Protein Concentration and Protein Localization Data
| R1 | R2 | R3 | ||||||||||||||||
|---|---|---|---|---|---|---|---|---|---|---|---|---|---|---|---|---|---|---|
| G1 Pre-START | G1 Post-START | S/G2 | Metaphase | Anaphase | Telophase | G1 Pre-START | G1 Post-START | S/G2 | Metaphase | Anaphase | Telophase | G1 Pre-START | G1 Post-START | S/G2 | Metaphase | Anaphase | Telophase | |
| Concentration | 5.9223 | 6.1399 | 5.7814 | 5.4529 | 5.9654 | 5.9806 | 5.4616 | 6.2334 | 6.2761 | 4.9291 | 4.8542 | 5.843 | 6.2483 | 6.6608 | 6.2499 | 5.6786 | 5.5376 | 6.8559 |
| Actin | 0.0004 | 0.0002 | 0 | 0 | 0.0006 | 0.0001 | 0.0301 | 0.0001 | 0.0037 | 0.0398 | 0.0081 | 0.0026 | 0.0013 | 0.0002 | 0.0138 | 0.0056 | 0.0083 | 0.0108 |
| Bud | 0.0029 | 0.0031 | 0.0001 | 0 | 0.0003 | 0.0001 | 0.0012 | 0.0028 | 0.0005 | 0.0003 | 0.0002 | 0.0006 | 0.0002 | 0.0001 | 0.0005 | 0.0019 | 0.0001 | 0.0002 |
| Bud Neck | 0.0039 | 0.0006 | 0.0004 | 0.0001 | 0.001 | 0.0015 | 0.0042 | 0.0005 | 0.0027 | 0.0009 | 0.0025 | 0.0039 | 0.0007 | 0.0003 | 0.0025 | 0.0027 | 0.002 | 0.0043 |
| Bud Periphery | 0.0006 | 0.0004 | 0 | 0 | 0.0003 | 0 | 0.0021 | 0.0003 | 0.0004 | 0.0004 | 0.0003 | 0.0003 | 0.0001 | 0 | 0.0007 | 0.001 | 0.0001 | 0.0002 |
| Bud Site | 0.0029 | 0.0015 | 0.0001 | 0 | 0.0009 | 0.0001 | 0.002 | 0.0015 | 0.0028 | 0.0035 | 0.0004 | 0.0003 | 0.0002 | 0.0004 | 0.0037 | 0.0025 | 0.0004 | 0.0004 |
| Cell Periphery | 0.0001 | 0.0001 | 0 | 0 | 0.0001 | 0 | 0.0004 | 0 | 0.0001 | 0.0001 | 0.0001 | 0 | 0 | 0 | 0.0002 | 0.0001 | 0.0001 | 0.0001 |
| Cytoplasm | 0.0293 | 0.1058 | 0.0448 | 0.0051 | 0.0392 | 0.0603 | 0.0658 | 0.1261 | 0.0713 | 0.0372 | 0.0222 | 0.0404 | 0.0406 | 0.0929 | 0.0609 | 0.0859 | 0.0227 | 0.0804 |
| Cytoplasmic Foci | 0.0009 | 0.0007 | 0.0004 | 0 | 0.0003 | 0.0003 | 0.0077 | 0.0007 | 0.0024 | 0.0009 | 0.0056 | 0.0036 | 0.0053 | 0.0002 | 0.0038 | 0.0523 | 0.001 | 0.0004 |
| Eisosomes | 0.0001 | 0 | 0 | 0 | 0 | 0 | 0.0004 | 0 | 0 | 0.0007 | 0.0005 | 0.0001 | 0 | 0 | 0.0002 | 0 | 0.0004 | 0.0001 |
| Endoplasmic Reticulum | 0.0007 | 0.0008 | 0.0009 | 0.0001 | 0.0021 | 0.0011 | 0.005 | 0.0012 | 0.0017 | 0.0005 | 0.0033 | 0.0015 | 0.0017 | 0.0013 | 0.0039 | 0.0033 | 0.0049 | 0.0017 |
| Endosome | 0.0016 | 0.0011 | 0.0015 | 0 | 0.0025 | 0.0013 | 0.0221 | 0.0017 | 0.0054 | 0.0007 | 0.0214 | 0.0079 | 0.0094 | 0.0006 | 0.0068 | 0.0114 | 0.0074 | 0.0032 |
| Golgi | 0.0001 | 0 | 0 | 0 | 0.0001 | 0 | 0.0045 | 0 | 0.0011 | 0.0012 | 0.006 | 0.0026 | 0.0008 | 0 | 0.0028 | 0.0067 | 0.0007 | 0.0012 |
| Lipid Particles | 0.0003 | 0 | 0 | 0 | 0.0001 | 0 | 0.0057 | 0 | 0.0047 | 0.0009 | 0.0122 | 0.0015 | 0.0066 | 0 | 0.0037 | 0.0103 | 0.0006 | 0.0009 |
| Mitochondria | 0.0005 | 0.0005 | 0.0002 | 0 | 0.0007 | 0.0002 | 0.0106 | 0.0003 | 0.0012 | 0.0119 | 0.0084 | 0.008 | 0.0008 | 0.0003 | 0.0023 | 0.0043 | 0.0047 | 0.0012 |
| None | 0.001 | 0.0019 | 0.0009 | 0 | 0.0004 | 0.0016 | 0.0118 | 0.0008 | 0.0012 | 0.0003 | 0.0172 | 0.002 | 0.001 | 0.0003 | 0.0004 | 0.0008 | 0.0299 | 0.0005 |
| Nuclear Periphery | 0.0109 | 0.0157 | 0.0145 | 0.0035 | 0.0279 | 0.0122 | 0.0275 | 0.0145 | 0.0122 | 0.0075 | 0.0218 | 0.012 | 0.0199 | 0.013 | 0.016 | 0.0114 | 0.0468 | 0.0123 |
| Nucleolus | 0.0028 | 0.0016 | 0.0011 | 0.0004 | 0.0021 | 0.0015 | 0.0044 | 0.0011 | 0.0014 | 0.0007 | 0.0052 | 0.0024 | 0.0012 | 0.0008 | 0.0008 | 0.0006 | 0.0047 | 0.0008 |
| Nucleus | 0.9278 | 0.8545 | 0.9279 | 0.99 | 0.9136 | 0.914 | 0.7641 | 0.8416 | 0.8774 | 0.8827 | 0.8416 | 0.895 | 0.8934 | 0.8828 | 0.8694 | 0.7654 | 0.8464 | 0.8772 |
| Peroxisomes | 0.0002 | 0 | 0 | 0 | 0 | 0 | 0.0026 | 0 | 0.001 | 0.0063 | 0.0045 | 0.0006 | 0.0063 | 0 | 0.0024 | 0.0262 | 0.0002 | 0.0003 |
| Punctate Nuclear | 0.0118 | 0.009 | 0.0059 | 0.0007 | 0.0046 | 0.0044 | 0.0194 | 0.0049 | 0.0065 | 0.0032 | 0.0163 | 0.0132 | 0.0082 | 0.0057 | 0.0027 | 0.0033 | 0.0162 | 0.0022 |
| Vacuole | 0.0009 | 0.002 | 0.001 | 0 | 0.0024 | 0.0011 | 0.0068 | 0.0014 | 0.0016 | 0.0003 | 0.0012 | 0.0009 | 0.0014 | 0.0009 | 0.0023 | 0.0031 | 0.0012 | 0.0012 |
| Vacuole Periphery | 0.0002 | 0.0004 | 0.0003 | 0 | 0.0007 | 0.0002 | 0.0019 | 0.0002 | 0.0005 | 0.0001 | 0.0011 | 0.0006 | 0.0006 | 0.0002 | 0.0004 | 0.001 | 0.0012 | 0.0004 |
Sequencing Data
| R1 | R2 | |||||||||
|---|---|---|---|---|---|---|---|---|---|---|
| G1 Post-START | S/G2 | Metaphase | Anaphase | Telophase | G1 Post-START | S/G2 | Metaphase | Anaphase | Telophase | |
| Gene Expression | 11.4187 | 23.6386 | 27.906 | 27.9684 | 27.272 | 38.4416 | 36.6663 | 32.6298 | 36.9356 | 28.3727 |
| Translational Efficiency | 2.3599 | 1.4403 | 1.1281 | 1.2662 | 1.3249 | 0.8982 | 1.1816 | 1.3441 | 1.1831 | 1.5253 |
Hit Data
| Dataset | Hit |
|---|---|
| Protein Concentration | ✘ |
| Protein Localization | ✘ |
| Gene Expression | ✘ |
| Translational Efficiency | ✘ |
Endocytosis
| Temp | Actin Patch (Sac6-tdTomato) | Cortical Patch (Sla1-GFP) | Late Endosome (Snf7-GFP) | Vacuole (Vph1-GFP) |
|---|---|---|---|---|
| 37℃ | ||||
| RT |
Cell Cycle Omics
CYCLoPs (Pho85-GFP)
| Gene / Allele | Actin Patch (Sac6-tdTomato) | Cortical Patch (Sla1-GFP) | Late Endosome (Snf7-GFP) | Vacuole (Sac6-tdTomato) |
|---|
| Gene | Images |
|---|
| Gene | Images |
|---|
Images are not yet available
Images are not yet available